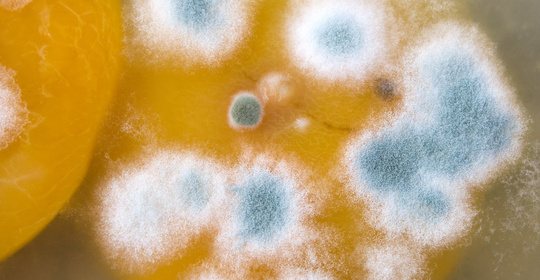

健康飲食
南瓜玉米湯:食材功效與制作方法




寶寶南瓜過敏症狀
寶寶對南瓜過敏,可能會出現皮膚症狀、消化系統症狀以及呼吸道症狀等。如果寶寶吃南瓜後出現不適症狀,建議及時到醫院就診,在醫生指導下進行冶癒。

寶寶南瓜饅頭的做法
寶寶南瓜饅頭的做法,一般有蒸、煮兩種。其中蒸的方法比較簡單,將南瓜泥和麵粉混合在一起揉成麵糰後進行發酵,再放入鍋中蒸熟即可食用。

南瓜番茄:燉飯秘訣與粥的功效
本文介紹了南瓜番茄燉飯的美味秘訣以及南瓜番茄粥的功效與作用。南瓜番茄燉飯的美味秘訣在於適量新增調味料、增加食材多樣性、調整烹飪時間和方法、使用新鮮食材等;而南瓜番茄粥則具有補充營養、促進消化、改善皮膚健康、緩解便秘、輔助控制血糖等功效與作用。
麵條:晚餐的選擇與注意事項




南瓜:兩款湯品,養生有道
本文介紹了兩款由南瓜製成的湯品——南瓜湯和南瓜番茄豬骨湯,這兩款湯品在秋季飲用有很好的養生效果。其中,南瓜湯主要由南瓜、雞肉、瑤柱、姜和清水組成;而南瓜番茄豬骨湯則加入了番茄和豬骨等食材。南瓜湯具有清熱解毒、潤肺止咳的功效,適合秋季乾燥的氣候。

寶寶南瓜蒸糕的做法
寶寶南瓜蒸糕的做法一般包括準備食材、將南瓜泥和麵粉混合攪拌、上鍋蒸熟等步驟。

寶寶能吃南瓜泥嗎
寶寶是否能吃南瓜泥,需要根據年齡進行判斷。如果寶寶小於6個月,則不建議新增輔食;如果大於6個月且已經新增過其他食物的寶寶可以適量食用。

寶寶濕疹可以吃南瓜嗎
寶寶濕疹是否可以吃南瓜,需要根據具體情況判斷。如果對南瓜不過敏,則一般是可以吃的;但如果對南瓜過敏,則不可以吃。
南瓜發黴:毒性、致癌、食物中毒

茶:邊吃瓜子邊喝茶的好處




寶寶濕疹能吃南瓜嗎
寶寶濕疹是否能吃南瓜,需要根據具體情況而定。如果對南瓜不過敏,則可以適量食用南瓜;但如果對南瓜過敏,則不建議食用。

南瓜石斑:特點與注意事項
本文介紹了三種不同型別的石斑魚——南瓜石斑魚、藍瓜石斑和黃瓜石斑魚及其相關的餌料選擇和食品安全注意事項。南瓜石斑魚可以採用多種方式烹製,但若出現異常應及時棄食;而藍瓜石斑則建議使用蝦、貝、烏賊、沙丁及青鱗等天然餌料進行飼養。從安全和健康的角度出發,瞭解每種石斑魚的特點並採取相應的措施是非常重要的。

冬季消化不良:原因與注意事項
本文介紹了冬季消化不良的原因及注意事項。在冬季,由於氣溫較低,人體的新陳代謝會減緩,導致胃腸蠕動速度變慢,進而影響食物的消化吸收。此外,冬季人們往往會選擇宅在家裡,減少了戶外活動的時間,這也會影響到腸胃的健康。針對這種情況,建議調整飲食結構,增加膳食纖維的攝入量,促進腸道蠕動,改善便秘症狀。

南瓜:小米菠菜粥、詹姆士、金瓜米粉
本文介紹了南瓜小米菠菜粥、南瓜米粉詹姆士以及金瓜米粉等食物,它們分別由南瓜、小米、菠菜為主要原料製作而成。這些食物不僅口感獨特,而且還具有豐富的營養價值,有助於補充身體所需的多種營養成分。需注意的是,儘管這些食物對健康有益,但仍需適量攝入,並且不能代替藥物進行疾病治療。
南瓜米糊:做法與營養價值



南瓜籽油:什麼時候吃、怎麼吃、有什麼好處




南瓜籽油:營養豐富,個體差異影響效果
本文介紹了Costco的南瓜籽油,一種從南瓜籽中提取的營養豐富的食用油,富含不飽和脂肪酸和維生素E,具有抗氧化功效,並能幫助維護心血管健康。然而,該油的具體效果因個人差異而異,取決於個體的飲食習慣和身體狀況。

寶寶消化不好能吃南瓜嗎
寶寶消化不好是否能吃南瓜,需要根據具體情況進行判斷。如果寶寶出現消化不良的症狀,則不建議食用南瓜。

南瓜籽粉:促進健康與成長發育的自然選擇
本文介紹了南瓜籽粉的主要功效及作用,其有助於改善消化功能、促進成長發育、維持骨骼健康、改善皮膚健康以及緩解攝護腺增生症狀。但如需使用南瓜籽粉進行治療或管理疾病時,務必先諮詢專業醫療人員的意見。